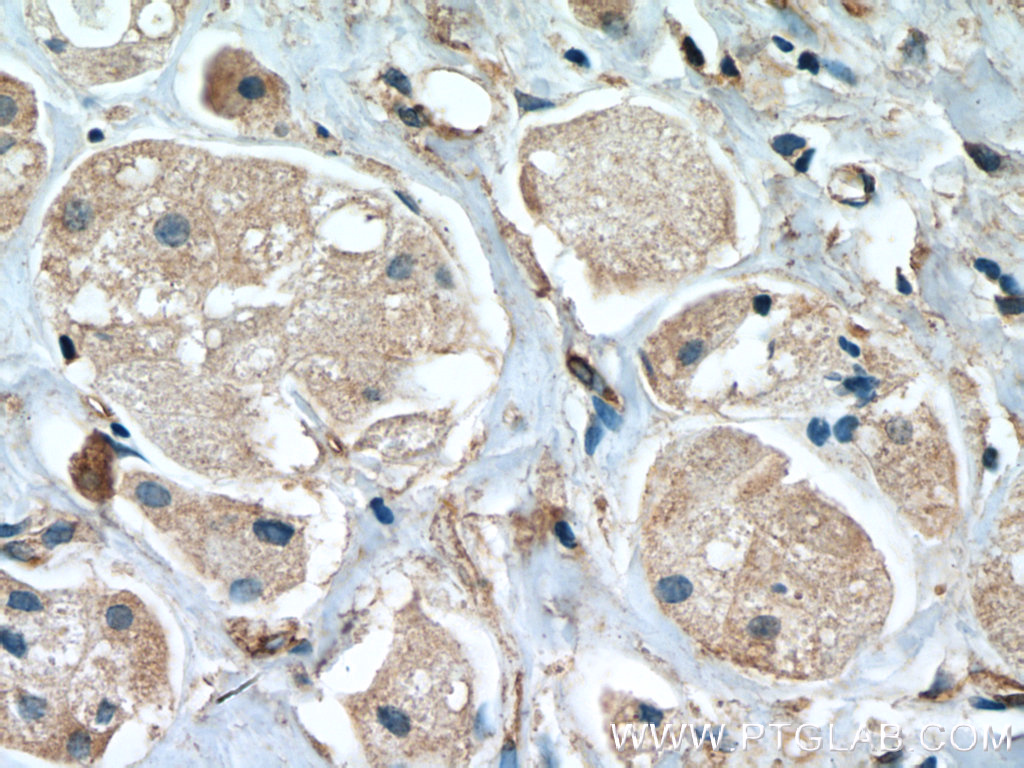

验证数据展示
经过测试的应用
| Positive WB detected in | HeLa cells, A431 cells, A549 cells, PC-3 cells, COLO 320 cells |
| Positive IHC detected in | human breast cancer tissue Note: suggested antigen retrieval with TE buffer pH 9.0; (*) Alternatively, antigen retrieval may be performed with citrate buffer pH 6.0 |
| Positive IF/ICC detected in | Ramos cells |
推荐稀释比
| 应用 | 推荐稀释比 |
|---|---|
| Western Blot (WB) | WB : 1:1000-1:4000 |
| Immunohistochemistry (IHC) | IHC : 1:200-1:800 |
| Immunofluorescence (IF)/ICC | IF/ICC : 1:400-1:1600 |
| It is recommended that this reagent should be titrated in each testing system to obtain optimal results. | |
| Sample-dependent, Check data in validation data gallery. | |
产品信息
66485-1-Ig targets STAT2 in WB, IP, IF, IHC, ELISA applications and shows reactivity with Human, mouse, rat samples.
| 经测试应用 | WB, IF, IHC, ELISA Application Description |
| 文献引用应用 | WB, IP, IF |
| 经测试反应性 | Human, mouse, rat |
| 文献引用反应性 | human, mouse, pig |
| 免疫原 |
CatNo: Ag10168 Product name: Recombinant human STAT2 protein Source: e coli.-derived, PGEX-4T Tag: GST Domain: 503-851 aa of BC051284 Sequence: QFSSYVGRGLNSDQLSMLRNKLFGQNCRTEDPLLSWADFTKRESPPGKLPFWTWLDKILELVHDHLKDLWNDGRIMGFVSRSQERRLLKKTMSGTFLLRFSESSEGGITCSWVEHQDDDKVLIYSVQPYTKEVLQSLPLTEIIRHYQLLTEENIPENPLRFLYPRIPRDEAFGCYYQEKVNLQERRKYLKHRLIVVSNRQVDELQQPLELKPEPELESLELELGLVPEPELSLDLEPLLKAGLDLGPELESVLESTLEPVIEPTLCMVSQTVPEPDQGPVSQPVPEPDLPCDLRHLNTEPMEIFRNCVKIEEIMPNGDPLLAGQNTVDEVYVSRPSHFYTDGPLMPSDF 种属同源性预测 |
| 宿主/亚型 | Mouse / IgG1 |
| 抗体类别 | Monoclonal |
| 产品类型 | Antibody |
| 全称 | signal transducer and activator of transcription 2, 113kDa |
| 别名 | ISGF 3, P113, STAT113, STAT2 |
| 计算分子量 | 851 aa, 98 kDa |
| 观测分子量 | 113 kDa |
| GenBank蛋白编号 | BC051284 |
| 基因名称 | STAT2 |
| Gene ID (NCBI) | 6773 |
| RRID | AB_2881851 |
| 偶联类型 | Unconjugated |
| 形式 | Liquid |
| 纯化方式 | Protein G purification |
| UNIPROT ID | P52630 |
| 储存缓冲液 | PBS with 0.02% sodium azide and 50% glycerol, pH 7.3. |
| 储存条件 | Store at -20°C. Stable for one year after shipment. Aliquoting is unnecessary for -20oC storage. |
背景介绍
STAT2, also named as p113, belongs to the transcription factor STAT family. It is a signal transducer and activator of transcription that mediates signaling by type I IFNs (IFN-alpha and IFN-beta). Following type I IFN binding to cell surface receptors, Jak kinases (TYK2 and JAK1) are activated, leading to tyrosine phosphorylation of STAT1 and STAT2. The phosphorylated STATs dimerize and associate with ISGF3G/IRF-9 to form a complex termed ISGF3 transcription factor, that enters the nucleus. ISGF3 binds to the IFN stimulated response element (ISRE) to activate the transcription of IF stimulated genes, which drive the cell in an antiviral state. It also interacts with CRSP2, CRSP6, Simian virus 5 protein V, rabies virus phosphoprotein, IFNAR1 and IFNAR2. Its interaction with dengue virus NS5 inhibits the phosphorylation of STAT2, and, when all viral proteins are present (polyprotein), STAT2 is targeted for degradation. The calculated molecular weight of STAT2 is 98 kDa, but phosphorylated STAT2 is about 100-113 kDa.
发表文章
| Species | Application | Title |
|---|---|---|
Int Immunopharmacol Silencing SIRT1 promotes the anti-HBV action of IFN-α by regulating Pol expression and activating the JAK-STAT signaling pathway | ||
Exp Eye Res Integrated analysis of murine cornea identifies JAK/STAT signaling pathway upregulated specifically in female Vitamin A Deficient mice | ||
PLoS Pathog Free ISG15 inhibits Pseudorabies virus infection by positively regulating type I IFN signaling | ||
J Nanobiotechnology Apoptotic tumor cell-derived microparticles loading Napabucasin inhibit CSCs and synergistic immune therapy |